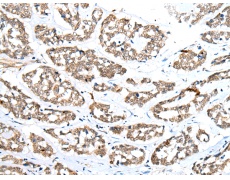
一抗

中文名稱:兔抗ZNRD1多克隆抗體
|
Background: |
This gene encodes a DNA-directed RNA polymerase I subunit. The encoded protein contains two potential zinc-binding motifs and may play a role in regulation of cell proliferation. The encoded protein may be involved in cancer and human immunodeficiency virus progression. Alternative splicing results in multiple transcript variants. |
|
Applications: |
ELISA, IHC |
|
Name of antibody: |
ZNRD1 |
|
Immunogen: |
Full length fusion protein |
|
Full name: |
zinc ribbon domain containing 1 |
|
Synonyms: |
TEX6; ZR14; HTEX6; Rpa12; hZR14; HTEX-6; TCTEX6; tctex-6 |
|
SwissProt: |
Q9P1U0 |
|
ELISA Recommended dilution: |
5000-10000 |
|
IHC positive control: |
Human esophagus cancer |
|
IHC Recommend dilution: |
20-100 |

 購物車
購物車 幫助
幫助
 021-54845833/15800441009
021-54845833/15800441009